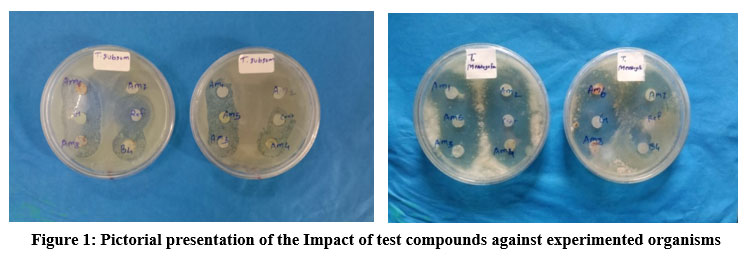

Introduction
Heterocyclic 1,2 nuclei are crucial building blocks for the development of numerous therapeutic medicines and play a significant role in medicinal chemistry. The central core of numerous significant biological molecules known as chalcones is an aromatic ketone. The α,β-unsaturated carbonyl system of chalcones and its analogues is recognized as a crucial framework and has been used as a precursor for molecules with physiological activity. The parent compound in the chalcone series is benzylidene acetophenone. Chalcones3,4,5,6,7,8 are the biogenetic precursors of flavonoids and isoflavonoids ,the natural and synthetic products that have been reviewed for their wide range of pharmacological activity9,10, medicinal11,12, and agricultural activities. Literature survey also reveals various biological activities13,14,15,16 like antibacterial17,18,19, antioxidant20, antifungal21,22,23,24,25,26, tubulin polymerisation inhibitors27, potent antitumor activity28, antimalarial agent29, antimicrobial30,31,32, anticancer33,34,35, antitubercular36, anti-infective properties37 in-vivo38, as well as in-vitro conditions39.
Plant pathology is the study of the causes, progression, and management of plant diseases. Plant diseases can be brought on by environmental factors or pathogenic organisms like fungi, bacteria, viruses, etc. Plants suffering from these diseases may grow more slowly or even die. Fungi were the first class of agents identified as causing plant diseases.
Materials and Methods
In our previous work, a series of novel substituted chalcones40 (listed in Table 1) were prepared by treating different aromatic aldehydes with different substituted acetophenones in presence of ethyl alcohol and aqueous potassium hydroxide (KOH) solution. These synthesized compounds were characterized by IR and 1H NMR spectra and assayed for their antibacterial activities. In continuation with our previous work, we undertake the antifungal activities these compounds.
Table 1: List of Synthesized Chalcones.
|
Sr No |
Code |
Synthesized Chalcones |
|
1 |
AM1 |
3-(2,3-Dichlorophenyl)-1-(4-methylphenyl)prop-2-en-1-one |
|
2 |
AM2 |
3-(4-Fluorophenyl)-1-phenylprop-2-en-1-one |
|
3 |
AM3 |
1-(2,4-Dihydroxyphenyl)-3-(3-nitrophenyl)prop-2-en-1-one |
|
4 |
AM4 |
1-(4-Methylphenyl)-3-(3-nitrophenyl)prop-2-en-1-one |
|
5 |
AM5 |
3-(4-Methoxyphenyl)-1-phenylprop-2-en-1-one |
|
6 |
AM6 |
1-(4-Bromophenyl)-3-(4-hydroxyphenyl)prop-2-en-1-one |
|
7 |
AM7 |
3-(4-Methoxyphenyl)-1-(4-methylphenyl)prop-2-en-1-one |
|
8 |
AM8 |
1-(4-Bromophenyl)-3-phenylprop-2-en-1-one |
|
9 |
B4 |
1-(3-Aminophenyl)-3-(4-chlorophenyl)prop-2-en-1-one |
|
10 |
G |
3-(4-Hydroxyphenyl)-1-(4-methylphenyl)prop-2-en-1-one |
|
11 |
H |
3-(2,3-Dichlorophenyl)-1-(2,4-dihydroxyphenyl)prop-2-en-1-one |
|
12 |
I |
3-(4-Chlorophenyl)-1-(4-methylphenyl)prop-2-en-1-one |
|
13 |
J |
1-(3-Aminophenyl)-3-(2,3-dichlorophenyl)prop-2-en-1-one |
|
14 |
K |
3-(2,3-Dichlorophenyl)-1-(4-methylphenyl)prop-2-en-1-one |
|
15 |
L |
3-(3-Nitrophenyl)-1-phenylprop-2-en-1-one |
|
16 |
M |
1-(3-Methylphenyl)-3-phenylprop-2-en-1-one |
|
17 |
N |
3-(4-Nitrophenyl)-1-phenylprop-2-en-1-one |
|
18 |
O |
1-(4-Bromophenyl)-3-(4-methoxyphenyl)prop-2-en-1-one |
|
19 |
P |
3-(4-Chlorophenyl)-1-(2,4-dihydroxyphenyl)prop-2-en-1-one |
Results
The synthesized chalcone derivatives were screened for their antifungal assay against some ornamental plant pathogens viz. Candida albicans, Trichophyton rubrum, Aspergillus niger, and Trichophyton mentagoforum.
Table 2: Impact of test compounds against plant pathogens (Fungi).
|
Test Compound |
Candida albicans |
Trichophyton rubrum |
Aspergillus Niger |
Trichophyton mentagoforum |
|
Compound 1 |
20mm |
16 mm |
19 mm |
20 mm |
|
Compound 2 |
19 mm |
— |
20 mm |
22 mm |
|
Compound 3 |
15 mm |
20 mm |
23 mm |
24 mm |
|
Compound 4 |
21 mm |
19 mm |
21 mm |
23 mm |
|
Compound 5 |
14 mm |
18 mm |
16 mm |
25 mm |
|
Compound 6 |
19 mm |
18 mm |
— |
26 mm |
|
Compound 7 |
— |
15 mm |
— |
28 mm |
|
Compound 8 |
15 mm |
— |
— |
— |
|
Compound 9 |
14 mm |
20 mm |
20 mm |
13 mm |
|
Compound 10 |
16 mm |
22 mm |
— |
22 mm |
|
Compound 11 |
— |
18 mm |
20 mm |
17 mm |
|
Compound 12 |
20 mm |
— |
18 mm |
22 mm |
|
Compound 13 |
18 mm |
20 mm |
— |
21 mm |
|
Compound 14 |
18 mm |
22 mm |
— |
18 mm |
|
Compound 15 |
21 mm |
18 mm |
17 mm |
24 mm |
|
Compound 16 |
19 mm |
17 mm |
20 mm |
17 mm |
|
Compound 17 |
20 mm |
19 mm |
18 mm |
16 mm |
|
Compound 18 |
13 mm |
18 mm |
— |
18 mm |
|
Compound 19 |
— |
20 mm |
21 mm |
21 mm |
|
Reference Antibiotic |
38 mm (Fluconazole) |
39 mm (Fluconazole) |
16 mm (Fluconazole) |
18 mm (Fluconazole) |
|
Control Disc (Chloroform) |
— |
— |
— |
— |
Diameter of inhibition zone (mm)
Discussion
The synthesized compounds listed in Table 1, when assayed against the ornamental plant pathogens (fungi) viz. C.albicans, T.rubrum, A.niger, and T.mentagoforum showed moderate to excellent activities.
|
Figure 1: Pictorial presentation of the Impact of test compounds against experimented organisms |
In general, compounds in Table 2 showed good antifungal actions against all the test organisms viz. C.albicans, T.rubrum, A.niger, and T.mentagoforum. In general, test compounds 4, 15 and 16 showed very good activities against all the experimented organisms viz C.albicans, T. rubrum, A. niger, and T. mentagoforum. All the test compounds had shown comparatively excellent inhibitory activities against T. mentagoforum. The test compound 4 showed excellent antifungal activity against C.albicans. The test compounds10 and 14 were very active against T. rubrum. The test compound 3 showed very good activity against A. niger. The test compounds 6 and 7 showed excellent activity against T. mentagoforum. In case of A.niger, and T.mentagoforum, some test compounds showed higher antifungal actions than reference antibiotic Fluconazole.
 |
Figure 2: Graphical representation of the Impact of test compounds against plant pathogens viz Candida albicans and Trichophyton rubrum. |
 |
Figure 3: Graphical representation of the Impact of test compounds against plant pathogens viz Aspergillus niger and Trichophyton mentagoforum |
Conclusion
Most of the test compounds were found to be highly active against the experimented fungi viz. C.albicans, T.rubrum, A.niger, and T.mentagoforum. Hence, all of these test compounds can be employed to treat diseases in ornamental plants brought on by these pathogens. Yet, it is advisable to do a more in-depth investigation in light of agricultural sciences.
Acknowledgement
The authors are grateful to Amolakchand Mahavidyalaya, Yavatmal for providing all the necessary facilities to carry out synthetic work. Samruddhi Microbial Diagnostic Lab., Amravati, Maharashtra for providing antifungal activities.
Conflict of Interest
There are no conflict of interest.
References
- De S., Niranjan Babu M., Suneel Babu T., Bhavya Sree R., Sai Kiran A., Reddy K. S. K. A review article on importance of heterocyclic compounds. Mintage journal of Pharmaceutical & Medical Sciences; 2016;5(2):18-27.
- Sharma S., Kaur S., Bansal T., Gaba J. Review on Synthesis of Bioactive Pyrazoline Derivatives. Chemical Science Transactions; 2014;3(3):861-875.
- Elkanzi N.A.A., Hrichi H., Aloyan R. A., Derafa W., Zahou F.M., Bakr R.B. Synthesis of Chalcones Derivatives and Their Biological Activities: A Review. ACS Omega; 2022;7:27769-27786.
CrossRef - Bukhari S.N.A. Synthesis and evaluation of new chalcones and oximes as anticancer agents. RSC Adv; 2022;12:10307-10320.
CrossRef - Dhaliwal J.S., Moshawih S. , Goh K.W.,Loy M.J. , Hossain M.S., Hermansyah A. , Kotra V. , Kifli N., Goh H.P., Dhaliwal S.K.S. , Yassin H., Ming L.C. Pharmacotherapeutics Applications and Chemistry of Chalcone Derivatives. Molecules; 2022;27:7062.
CrossRef - Sashidhara K.V., Manoj Kumar, Abdhesh Kumar. A novel route to synthesis of flavones from salicylaldehyde and acetophenone derivatives. Tetrahedron Letter; 2012;53(18): 2355-2359.
CrossRef - Mokle S. S., Vibhute Y.B. Synthesis of some new biologically active chalcones and flavones. Der Pharma Chemica; 2009;1(2):145-152.
- Farooq S., Ngaini Z. Recent Synthetic Methodologies for Chalcone Synthesis (2013-2018).Current Organocatalysis; 2019;6:184-192.
CrossRef - Taresh B.H. Synthesis, Pharmacological Activity and Uses of Chalcone Compounds: A Review, Scientific Journal of Medical Research; 2022;6(21):43-46.
- Goyal K., Kaur R., Goyal A., Awasthi R. Chalcones: A review on synthesis and pharmacological activities. Journal of Applied Pharmaceutical Science; 2021;11(1):001-014.
- Rammohan , Reddy J. S., Sravya G., Rao C. N., Zyryanov G.V. Chalcone synthesis, properties and medicinal applications: a review. Environmental Chemistry Letters; 2020;18(2):433-458.
CrossRef - Chavan B.B., Gadekar A.S., Mehta P.P., Vawhal P.K., Kolsure A.K., Chabukswar A.R. Synthesis and Medicinal Significance of Chalcones-A Review. Asian Journal of Biomedical and Pharmaceutical Sciences; 2016;6(56):01-07.
- Jaiswal P., Pathak D.P., Bansal H., Agarwal U. Chalcone and their Heterocyclic Analogue: A Review Article. Journal of Chemical and Pharmaceutical Research; 2018; 10(4):160-173
- Verma S., Srivastava A.K., Pandey O.P. A Review on Chalcones Synthesis and their Biological Activity. Pharma Tutor; 2018; 6(2): 22-39
CrossRef - Chopra P.K.P.G. Chalcones: A brief review. International Journal of Research in Engineering and Applied Sciences; 2016;6(5):173-185.
CrossRef - Jung, Lee Y., Min D., Jung M., Oh S. Practical Synthesis of Chalcone Derivatives and Their Biological Activities. Molecules;2017;22(11):1872.
CrossRef - Koudokpon H., Armstrong N., Dougnon T.V., Fah L., Hounsa E., Bankole H.S., Loko F., Chabriere E., Rolain J.M. Antibacterial Activity of Chalcone and Dihydrochalcone Compounds from Uvaria chamae Roots against Multidrug-Resistant Bacteria. BioMed Research International; 2018:Article ID 1453173.
CrossRef - Sampaio de Freitas, Jayze da Cunha Xavier , Pereira R.L.S., Rocha J.E., Muniz D. F., Priscila T da Silva, Joao P da Hora, Helcio S dos Santos, Bandeira P. N., Nogueira C.E.S., Teixeira A.M.R., Coutinho H.D.M. Direct antibacterial and antibiotic resistance modulatory activity of chalcones synthesized from the natural product2-hydroxy-3,4,6-trimethoxyacetophenone. FEMS Microbiology Letters; 2020;367(15):1-8.
CrossRef - Shah (Gala) P.R., Phadke S., Borole P. Synthesis of New Chalcone Derivatives as Antibacterial Agents. J. Pharm. Phytopharmacol. Res; 2014;4(2): 95-99.
- Mohana D, Subashini P, Thamizh Thendral M and Syed Shafi. Design and Synthesis of novel Chalcone Derivatives and their Antioxidant Activity. IOSR Journal of Pharmacy and Biological Sciences; 2018;13(5-III):25-28.
- Gupta D, Jain D. K. Chalcone derivatives as potential antifungal agents: Synthesis, and antifungal activity. J Adv Pharm Technol Res; 2015;6:114-7.
CrossRef - LaguB., Yejella R.P., Bhandare R.R., Shaik A.B. Novel triflouromethyl and triflouromethoxy substituted chalcone derivatives. Pharmaceuticals; 2020;13(11):375.
CrossRef - Geweely N.S., Soliman M.M., Ali R.A., Hassaneen H.M., Abdelhamid I.A. Novel eco‑friendly [1,2,4]triazolo[3,4‑a]isoquinoline chalcone derivatives effciency against fungal deterioration of ancient Egyptian mummy cartonnage, Egypt. Archives of Microbiology; 2023;205:57
CrossRef - Jacob B.S.,Victoria A.E., Deboh E. D. Preparation and Antifungal Properties of Chalcone and Halogenated Derivatives. Saudi J Med Pharm Sci; 2020;6(4):379-389.
CrossRef - Manjunath G., Mahesh M., Bheemaraju G., Venkataramana P. Synthesis of New Pyrazole Derivatives Containing Quinoline Moiety via Chalcones: A Novel Class of Potential Antibacterial and Antifungal Agents. Chem Sci Trans; 2016;5(1):61-74.
- Panchal A.D., Kunjadia P.D., Patel P.M. Synthesis and Biological Evaluation of Chalcone Derivatives Linked Triazoles. International Journal of Pharmaceutical Sciences and Drug Research; 2011;3(4):331-337
- Liua W., Hea M., Lic Y., Pengd Z., Wang G. A review on synthetic chalcone derivatives as tubulin polymerisation inhibitors. Journal of enzyme inhibition and medicinal chemistry; 2022;37(1): 9-38.
CrossRef - Xiao JQ, Gao MX, Diao Q. Chalcone derivatives and their activities against drug-resistant cancers: an overview. Curr Top Med Chem; 2021;21:348–62.
CrossRef - Syahri J., Nasution H., Nurohmah B. A., Purwono B., Yuanita E. Novel aminoalkylated chalcone: Synthesis, biological evaluation, and docking simulation as potent antimalarial agents. Journal of Applied Pharmaceutical Science; 2020;10(06):001-005.
CrossRef - Ozdemir, Altıntop M.D., Sever B., Gencer H.K., Kapkac H. A., Atlı O., Baysal M. A New Series of Pyrrole-Based Chalcones: Synthesis and Evaluation of Antimicrobial Activity, Cytotoxicity and Genotoxicity. Molecules; 2017;22(12):2112.
CrossRef - Shinde R. S., Dake S. A., Pawar R. P. Design, Synthesis and Antimicrobial Activity of Some Triazine Chalcone Derivatives. Anti-Infective Agents; 2020;18:332-338.
CrossRef - Pereira, Duraes F., Szemeredi N., Freitas-da-Silva J., Pinto E, Martins-da-Costa P., Pinto M., Correia-da-Silva M., Spengler G., Sousa E., Cidade H. New Chalcone–Triazole Hybrids with Promising Antimicrobial Activity in Multidrug Resistance Strains. Int. J. Mol. Sci; 2022;23(22):14291.
CrossRef - Helmy M.T., Sroor F.M., Mahrous K.F., Mahmoud K., Hassaneen H.M., Saleh F.M., Abdelhamid I.A., Teleb M.A.M., Anticancer activity of novel 3-(furan-2-yl)pyrazolyl and 3‐(thiophen‐2‐yl)pyrazolyl hybrid chalcones: Synthesis and in vitro Arch. Pharm; 2022;355:e2100381.
CrossRef - Constantinescu T., Lungu C.N. Anticancer Activity of Natural and Synthetic Chalcones. J. Mol. Sci; 2021; 22:11306.
CrossRef - Noser A.A., Shehadi I. A., Abdelmonsef A.H., Salem M. M. Newly Synthesized Pyrazolinone Chalcones as Anticancer Agents via Inhibiting the PI3K/Akt/ERK1/2 Signaling Pathway. ACS Omega; 2022; 7:25265−25277.
CrossRef - Lokesh B. V., Prasad R. Y., Shaik A. B. Novel Pyrimidine derivatives from 2,5-dichloro,3-acetylthienyl chalcones as antifungal, antitubercular and cytotoxic agents: Design, synthesis, biological activity and docking study. Asian J. Chem; 2019;31(6):1212-1220.
CrossRef - Hellewell L., Bhakta S. Chalcones, stilbenes and ketones have anti-infective properties via inhibition of bacterial drug-efflux and consequential synergism with antimicrobial agents; Access Microbiology. 2020;2.
CrossRef - Kahssay S.W., Solomon G., Desta H.K.T. Design, Synthesis, Characterization and in vivo Antidiabetic Activity Evaluation of Some Chalcone Derivatives. Drug Design, Development and Therapy; 2021;15:3119-3129.
CrossRef - Higgs J., Wasowski C., Marcos A., Jukic M., Pavan C.H., Gobec S., Pinto F. de T., Colettis N., Marder M., Chalcone derivatives: synthesis, in vitro and in vivo evaluation of their anti-anxiety, anti-depression and analgesic effects. heliyon; 2019:e01376.
CrossRef - Bhade M. W., Badnakhe C.D., Khan H., Chide D., Dahake D., Gore N. Synthesis and characterization of some novel chalcone derivatives as antibacterial agents. Vidyabharati International Interdisciplinary Research Journal; 2022 Special issues,SP 2022 Part-7:1493-1497.

